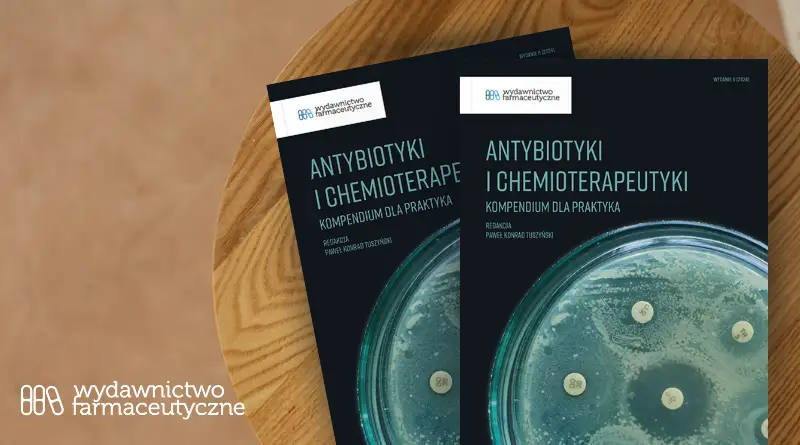

Podręcznik Antybiotyki i chemioterapeutyki – Kompendium dla praktyka omawia zasady współczesnej antybiotykoterapii. Tematy dotyczą praktycznych aspektów stosowania antybiotyków i chemioterapeutyków, takich jak probiotykoterapia, zakażenia grzybicze towarzyszące antybiotykoterapii, profilaktyczna antybiotykoterapia, wskazówki dotyczące rozróżniania etiologii chorób o podobnych objawach, a także substancje antybiotyczne dostępne bez recepty czy też zastosowania off-label. Podręcznik został podzielony na 3 części co sprawia, że korzystanie z niego jest bardzo przyjemne.
Przeczytaj recenzję redaktora prowadzącego podręcznika i odwiedź stronę, aby skorzystać z promocji.
Recenzja podręcznika „Antybiotyki i chemioterapeutyki. Kompendium dla praktyka.”
Farmaceuta szukający informacji o antybiotykach może zasięgnąć do ChPL, ulotek leków, farmakopei czy podręczników do farmakologii. Dominująca część tych źródeł podaje informacje niekompletne lub nieaktualne, a przeglądanie dziesiątek stron wytycznych jest bardzo czasochłonne i trudne do zrealizowania w codziennej praktyce aptekarskiej. Brakuje zatem jednego kompleksowego źródła, w którym farmaceuta potrzebujący znaleźć informację na temat jednego konkretnego leku lub antybiotykoterapii konkretnej infekcji bakteryjnej. Podręcznik Antybiotyki i chemioterapeutyki. Kompendium dla praktyka wypełnia tę lukę. W publikacji zostają streszczone i omówione wszystkie aspekty leków przeciwbakteryjnych, jakie mogą być potrzebne w opiece farmaceuty nad pacjentem z infekcją bakteryjną. Zamysł podręcznika kładł nacisk na praktyczne wykorzystanie zawartych w nim informacji i dzięki licznym wskazówkom praktycznym i zestawieniom aktualnie dostępnych w obrocie preparatów zamysł został zrealizowany. Nie oznacza to jednak, że czytelnikiem podręcznika może być tylko farmaceuta. Z zawartych w nim informacji może także skorzystać technik farmaceutyczny, lekarz oraz pielęgniarka. Będzie on także cenną pozycją na półce studenta farmacji, ponieważ wieloaspektowe podejście do omawianych leków pozwoli skutecznie uczyć się na farmakologię, czy farmakoterapię.
Praca nad tym podręcznikiem oczywiście nie należała do łatwych zadań. Zapewnienie aktualności treści w myśl evidence based medicine wymaga złożonego przeglądu literatury oraz dogłębnej weryfikacji informacji. Efekt jest jednak warty włożonej w niego pracy, ponieważ kompendium wyczerpująco opisuje każdą grupę antybiotyków i chemioterapeutyków oraz w przejrzysty sposób pokazuje schematy antybiotykoterapii zgodne z najnowszymi wytycznymi.
W tym momencie trwa promocja, która umożliwia kupno tego podręcznika za jedyne 149 zł, czasu jest niewiele, bo tylko do 6 października, także nie czekaj łap za okazje.